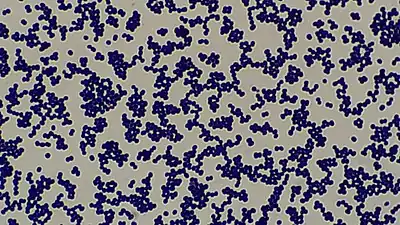

Staphylococcal infection
| Staphylococcal infection | |
|---|---|
![]() | |
| SEM micrograph of S. aureus colonies; the grape-like clustering is common to Staphylococcus species. | |
| Specialty | Infectious disease |
| Symptoms | Redness, pus, swelling, and tenderness |
| Types | Localized skin infection, diffuse skin infection, Toxinoses |
| Causes | Weakened immune system, open wounds |
| Diagnostic method | Culture, imaging test |
| Treatment | Antibiotic |
A staphylococcal infection or staph infection is an infection caused by members of the Staphylococcus genus of bacteria. These bacteria commonly inhabit the skin and nose where they are innocuous, but may enter the body through cuts or abrasions which may be nearly invisible. Once inside the body, the bacteria may spread to a number of body systems and organs, including the heart, where the toxins produced by the bacteria may cause cardiac arrest. Once the bacterium has been identified as the cause of the illness, treatment is often in the form of antibiotics and, where possible, drainage of the infected area. However, many strains of this bacterium have become antibiotic resistant; for those suffering these kinds of infection, the body's own immune system is the only defense against the disease. If that system is weakened or compromised, the disease may progress rapidly.[1] Anyone can contract Staph, but pregnant women, children, and people with chronic diseases or who are immuno-deficient are often more susceptible to contracting an infection.[2]
Types



| Main Staphylococcus aureus infections | |
|---|---|
| Type | Examples |
| Localized skin infections |
|
| Diffuse skin infection | |
| Deep, localized infections |
|
| Other infections |
|
| Toxinoses | |
| Unless otherwise specified in boxes, then reference is Lippincott's Illustrated Reviews: Microbiology (2007).[6] | |
Other infections include:
- Closed-space infections of the fingertips, known as paronychia.[7]
- Suspected involvement in atopic dermatitis (eczema)[8]
Signs and symptoms
Staph infection is typically characterized by redness, pus, swelling, and tenderness in areas of the infection. But, each type of skin infection caused by staph bacteria is different.[9]
A few common skin infections caused by staph bacteria are:
- Boils – Boils are the most common type of staph infection, they are pockets of white pus that start where a hair follicle or oil gland is. The boil is tender and red where the infection is located on the skin.[9][10]
- Impetigo – Impetigo is most prominent among children, and is usually located around their mouth, nose, hands, and feet. It shows up like a rash of painful blisters, will eventually produce pus that is yellowish in color.[9][11]
- Cellulitis – Cellulitis is also rash-like; the skin that is infected will be red, swollen, and usually warm to the touch. Cellulitis commonly infects the lower legs, but can also, less commonly, affect the face and arms.[9][12]
- Staphylococcus scalded skin syndrome – Staphylococcus scalded skin syndrome is caused by toxins produced when a staph infection gets too severe. It is characterized by a fever, rash, and blisters.[13][14]
- Methicillin-resistant Staphylococcus aureus (MRSA) – MRSA is one of the most common antibiotic-resistant strains of staph bacteria. MRSA causes rashes, boils, sores, and other abscesses.[9][15]
Staphylococcal infection of atopic dermatitis
Impetigo rash
Cellulitis rash
Causes
Staph infections have a multitude of different causes, such as:
- Open wounds – This is by far the biggest cause of staph infection, as any open wound, even ones as small as a paper cut, are vulnerable to being infected. Staph bacteria will enter the body through any open wound, so it is important to properly treat, disinfect, and bandage any wounds.[16][17]
- Contact with infected persons or surfaces – Staph infections are very contagious when in contact with a person that is already infected. A person with staph infection is contagious until the bacteria are completely out of their body; it is common to see the spread of staph in contact sports.[18][16]
- Weakened immune system – Anyone with a weakened immune system for any reason can be more easily affected by staph bacteria, because their bodies are unable to defend against infectious bacteria as well[19][20]
- Unwashed linens – Staph bacteria are very resistant under harsh conditions, and they will cling to objects where they can create a niche. Unwashed bath towels, blanket, bed sheets, and clothes can create a great environment for these bacteria to grow.[21][17]
- Infection after surgery – Hospitals are a very common place for staph bacteria to contaminate; this becomes problematic when people are in surgery, because in some cases staph can be introduced to a person's body when an incision is opened.[22]
- Invasive devices – Medical devices that have any connection to organs to the outside of the body are very problematic, because they allow an easy open pathway into the body, examples of these devices are; catheters, dialysis tubing, feeding tubes, breathing tubes, etc.[23][24]
Diagnosis
In terms of the diagnosis of Staph infection we find that the following is done:[9]
- Physical exam
- Culture
- Skin scraping
- Tissue sample
- Stool sample
- Nasal swabs
- Imaging tests
Classification
Coagulase-positive
The main coagulase-positive staphylococcus is Staphylococcus aureus,[25] although not all strains of Staphylococcus aureus are coagulase positive. These bacteria can survive on dry surfaces, increasing the chance of transmission. S. aureus is also implicated[9] in toxic shock syndrome; during the 1980s some tampons allowed the rapid growth of S. aureus, which released toxins that were absorbed into the bloodstream. Any S. aureus infection can cause the staphylococcal scalded skin syndrome, a cutaneous reaction to exotoxin absorbed into the bloodstream. It can also cause a type of septicaemia called pyaemia. The infection can be life-threatening. Problematically, methicillin-resistant Staphylococcus aureus (MRSA) has become a major cause of hospital-acquired infections. MRSA has also been recognized with increasing frequency in community-acquired infections.[26] The symptoms of a Staph Infection include a collection of pus, such as a boil or furuncle, or abscess. The area is typically tender or painful and may be reddened or swollen.[27]
Coagulase-negative

- S. epidermidis, a coagulase-negative staphylococcus species, is a commensal of the skin, but can cause severe infections in immune-suppressed individuals and those with central venous catheters.[24][28]
- S. saprophyticus, another coagulase-negative species that is part of the normal vaginal flora, is predominantly implicated in uncomplicated lower genitourinary tract infections in young sexually active women.[29]
- Other staphylococcal species have been implicated in human infections, notably S. lugdunensis, S. schleiferi.[30]
Treatment
Treatment for staph infection varies depending on the type and severity of infection, common treatments are antibiotics, topical creams, and drainage/cleaning of infectious wounds.[31][32]
For susceptible strains, the treatment of choice for S. aureus infection is penicillin. An antibiotic derived from some Penicillium fungal species, penicillin inhibits the formation of peptidoglycan cross-linkages that provide the rigidity and strength in a bacterial cell wall. The four-membered β-lactam ring of penicillin is bound to enzyme DD-transpeptidase, an enzyme that when functional, cross-links chains of peptidoglycan that form bacterial cell walls. The binding of β-lactam to DD-transpeptidase inhibits the enzyme's functionality and it can no longer catalyze the formation of the cross-links. As a result, cell wall formation and degradation are imbalanced, thus resulting in cell death. In most countries, however, penicillin resistance is extremely common , and first-line therapy is most commonly a penicillinase-resistant β-lactam antibiotic or vancomycin, depending on local resistance patterns. Combination therapy with gentamicin may be used to treat serious infections, such as endocarditis.[33][34]
Epidemiology

Staphylococcus bacteria is one of the leading community-acquired bacteria. According to the CDC, after a push from hospitals to better prevent staph infections, the percentage of people affected has dropped dramatically. However, staph infections are still prominent and a cause for concern among healthcare professionals, especially new antibiotic-resistant strains. [36][37][38]
In the United States, in 2017 some 119,000 people suffered from bloodstream Staphylococcus aureus[18] whereas other industrialized countries have an average incidence rate of 10 to 30 per 100,000 person-years.[36]
Etymology
The generic name Staphylococcus is derived from the Greek word "staphyle", meaning bunch of grapes, and "kokkos", meaning granule. [39]
The bacteria, when seen under a microscope, appear like a branch of grapes[40]
References
- ↑ "Staph infections". Mayo Clinic. Archived from the original on 2021-06-01. Retrieved 2021-06-14.
- ↑ Smith, Barbara (6 June 2014). Nursing & Health Survival Guide: Infection Control. Routledge. p. 18. ISBN 978-1-317-90614-8. Archived from the original on 31 December 2022. Retrieved 31 December 2022.
- ↑ Kurono, Y.; Tomonaga, K.; Mogi, G. (1988-11-01). "Staphylococcus epidermidis and Staphylococcus aureus in otitis media with effusion". Archives of Otolaryngology–Head & Neck Surgery. 114 (11): 1262–1265. doi:10.1001/archotol.1988.01860230056023. ISSN 0886-4470. PMID 3262358.
- ↑ Pastacaldi, C.; Lewis, P.; Howarth, P. (2011-04-01). "Staphylococci and staphylococcal superantigens in asthma and rhinitis: a systematic review and meta-analysis". Allergy. 66 (4): 549–555. doi:10.1111/j.1398-9995.2010.02502.x. ISSN 1398-9995. PMID 21087214. S2CID 30042019.
- ↑ Payne, Spencer C.; Benninger, Michael S. (2007-11-15). "Staphylococcus aureus Is a Major Pathogen in Acute Bacterial Rhinosinusitis: A Meta-Analysis". Clinical Infectious Diseases. 45 (10): e121–e127. doi:10.1086/522763. ISSN 1058-4838. PMID 17968816.
- ↑ Fisher, Bruce; Harvey, Richard P.; Champe, Pamela C. (2007). Lippincott's Illustrated Reviews: Microbiology. Lippincott's Illustrated Reviews. Hagerstown, Maryland: Lippincott Williams & Wilkins. p. 349. ISBN 978-0-7817-8215-9.
- ↑ Dulski, Anne; Edwards, Christopher W. (2022). "Paronychia". StatPearls. StatPearls Publishing. Archived from the original on 15 August 2022. Retrieved 30 December 2022.
- ↑ Kim, Jihyun; Kim, Byung Eui; Ahn, Kangmo; Leung, Donald Y. M. (September 2019). "Interactions Between Atopic Dermatitis and Staphylococcus aureus Infection: Clinical Implications". Allergy, Asthma & Immunology Research. 11 (5): 593–603. doi:10.4168/aair.2019.11.5.593. ISSN 2092-7355. Archived from the original on 14 September 2021. Retrieved 30 December 2022.
- 1 2 3 4 5 6 7 "Staphylococcal Infections". medlineplus.gov. Archived from the original on 19 December 2022. Retrieved 24 December 2022.
- ↑ Boils and carbuncles: Overview. Institute for Quality and Efficiency in Health Care (IQWiG). 14 June 2018. Archived from the original on 17 December 2022. Retrieved 2 January 2023.
- ↑ "Impetigo: All You Need to Know | CDC". www.cdc.gov. 18 November 2022. Archived from the original on 28 December 2022. Retrieved 2 January 2023.
- ↑ "Cellulitis: All You Need to Know | CDC". www.cdc.gov. 18 November 2022. Archived from the original on 8 July 2021. Retrieved 2 January 2023.
- ↑ "Scalded skin syndrome: MedlinePlus Medical Encyclopedia". medlineplus.gov. Archived from the original on 25 December 2022. Retrieved 27 December 2022.
- ↑ Ross, Adam; Shoff, Hugh W. (2022). "Staphylococcal Scalded Skin Syndrome". StatPearls. StatPearls Publishing. Archived from the original on 16 December 2022. Retrieved 2 January 2023.
- ↑ "MRSA | CDC". www.cdc.gov. 5 February 2019. Archived from the original on 19 December 2022. Retrieved 2 January 2023.
- 1 2 "Staph infections - self-care at home: MedlinePlus Medical Encyclopedia". medlineplus.gov. Archived from the original on 24 December 2022. Retrieved 29 December 2022.
- 1 2 "Staph infections in the hospital: MedlinePlus Medical Encyclopedia". medlineplus.gov. Archived from the original on 29 July 2022. Retrieved 3 January 2023.
- 1 2 "Staph infections can kill". Centers for Disease Control and Prevention. 22 March 2019. Archived from the original on 30 October 2022. Retrieved 27 December 2022.
- ↑ Cant, Andrew; Cole, Theresa (2010). "Infections in the Immunocompromised". Hot Topics in Infection and Immunity in Children VI. 659: 1–18. doi:10.1007/978-1-4419-0981-7_1. Archived from the original on 26 December 2022. Retrieved 26 December 2022.
- ↑ Sasson, G.; Bai, A. D.; Showler, A.; Burry, L.; Steinberg, M.; Ricciuto, D. R.; Fernandes, T.; Chiu, A.; Raybardhan, S.; Science, M.; Fernando, E.; Morris, A. M.; Bell, C. M. (July 2017). "Staphylococcus aureus bacteremia in immunosuppressed patients: a multicenter, retrospective cohort study". European Journal of Clinical Microbiology & Infectious Diseases: Official Publication of the European Society of Clinical Microbiology. 36 (7): 1231–1241. doi:10.1007/s10096-017-2914-y. ISSN 1435-4373. Archived from the original on 15 June 2022. Retrieved 26 December 2022.
- ↑ Abney, Sarah E.; Ijaz, M. Khalid; McKinney, Julie; Gerba, Charles P. (25 June 2021). "Laundry Hygiene and Odor Control: State of the Science". Applied and Environmental Microbiology. 87 (14): e03002–20. doi:10.1128/AEM.03002-20. Archived from the original on 27 September 2022. Retrieved 27 December 2022.
- ↑ Zabaglo, Mate; Sharman, Tariq (2022). "Postoperative Wound Infection". StatPearls. StatPearls Publishing. Archived from the original on 2 August 2022. Retrieved 26 December 2022.
- ↑ Australia, Healthdirect (10 May 2021). "Invasive staph infections". www.healthdirect.gov.au. Archived from the original on 26 October 2022. Retrieved 28 December 2022.
- 1 2 Lee, Ezra; Anjum, Fatima (2022). "Staphylococcus Epidermidis". StatPearls. StatPearls Publishing. Archived from the original on 15 April 2022. Retrieved 26 December 2022.
- ↑ Władyka, Benedykt; Bonar, Emilia (1 January 2018). "Chapter 21 - Application of Staphylococci in the Food Industry and Biotechnology". Pet-To-Man Travelling Staphylococci. Academic Press. pp. 281–291. ISBN 978-0-12-813547-1. Retrieved 8 January 2023.
- ↑ Sahebnasagh R, Saderi H, Owlia P. Detection of methicillin-resistant Staphylococcus aureus strains from clinical samples in Tehran by detection of the mecA and nuc genes. The First Iranian International Congress of Medical Bacteriology; 4–7 September; Tabriz, Iran. 2011. 195 pp.
- ↑ "Staph Infection". MedicineNet. WebMD. Archived from the original on 2021-06-01. Retrieved 2021-06-14.
- ↑ Ziebuhr, Wilma; Hennig, Susanne; Eckart, Martin; Kränzler, Hennes; Batzilla, Christoph; Kozitskaya, Svetlana (August 2006). "Nosocomial infections by Staphylococcus epidermidis: how a commensal bacterium turns into a pathogen". International Journal of Antimicrobial Agents. 28 Suppl 1: S14–20. doi:10.1016/j.ijantimicag.2006.05.012. ISSN 0924-8579. Archived from the original on 26 July 2022. Retrieved 26 December 2022.
- ↑ Becker K, Heilmann C, Peters G (October 2014). "Coagulase-negative staphylococci". Clin. Microbiol. Rev. 27 (4): 870–926. doi:10.1128/CMR.00109-13. PMC 4187637. PMID 25278577.
- ↑ Fleurette, J.; Bès, M.; Brun, Y.; Freney, J.; Forey, F.; Coulet, M.; Reverdy, M. E.; Etienne, J. (February 1989). "Clinical isolates of Staphylococcus lugdunensis and S. schleiferi: bacteriological characteristics and susceptibility to antimicrobial agents". Research in Microbiology. 140 (2): 107–118. doi:10.1016/0923-2508(89)90044-2. ISSN 0923-2508. Archived from the original on 27 July 2022. Retrieved 28 December 2022.
- ↑ David, Michael Z.; Daum, Robert S. (2017). "Treatment of Staphylococcus aureus Infections". Current Topics in Microbiology and Immunology. 409: 325–383. doi:10.1007/82_2017_42. ISSN 0070-217X. Archived from the original on 24 December 2022. Retrieved 26 December 2022.
- ↑ Liu, Catherine; Bayer, Arnold; Cosgrove, Sara E.; Daum, Robert S.; Fridkin, Scott K.; Gorwitz, Rachel J.; Kaplan, Sheldon L.; Karchmer, Adolf W.; Levine, Donald P.; Murray, Barbara E.; Rybak, Michael J.; Talan, David A.; Chambers, Henry F. (1 February 2011). "Clinical Practice Guidelines by the Infectious Diseases Society of America for the Treatment of Methicillin-Resistant Staphylococcus aureus Infections in Adults and Children". Clinical Infectious Diseases. 52 (3): e18–e55. doi:10.1093/cid/ciq146. Archived from the original on 8 December 2022. Retrieved 30 December 2022.
- ↑ Korzeniowski O, Sande MA (October 1982). "Combination antimicrobial therapy for Staphylococcus aureus endocarditis in patients addicted to parenteral drugs and in nonaddicts: A prospective study". Annals of Internal Medicine. 97 (4): 496–503. doi:10.7326/0003-4819-97-4-496. PMID 6751182.
- ↑ Bayer AS, Bolger AF, Taubert KA, Wilson W, Steckelberg J, Karchmer AW, et al. (1998). "Diagnosis and management of infective endocarditis and its complications". Circulation. 98 (25): 2936–2948. doi:10.1161/01.CIR.98.25.2936. PMID 9860802.
- ↑ Gutierrez, Kathleen; Halpern, Meira S.; Sarnquist, Clea; Soni, Shila; Arroyo, Anna Chen; Maldonado, Yvonne (January 2013). "Staphylococcal infections in children, California, USA, 1985-2009". Emerging Infectious Diseases. 19 (1): 10–20, quiz 185. doi:10.3201/eid1901.111740. ISSN 1080-6059. Retrieved 28 December 2022.
- 1 2 Tong, Steven Y. C.; Davis, Joshua S.; Eichenberger, Emily; Holland, Thomas L.; Fowler, Vance G. (July 2015). "Staphylococcus aureus infections: epidemiology, pathophysiology, clinical manifestations, and management". Clinical Microbiology Reviews. 28 (3): 603–661. doi:10.1128/CMR.00134-14. ISSN 1098-6618. Archived from the original on 2022-10-17. Retrieved 2022-12-26.
- ↑ Kourtis, Athena P. (2019). "Vital Signs: Epidemiology and Recent Trends in Methicillin-Resistant and in Methicillin-Susceptible Staphylococcus aureus Bloodstream Infections — United States". MMWR. Morbidity and Mortality Weekly Report. 68. doi:10.15585/mmwr.mm6809e1. ISSN 0149-2195. Archived from the original on 13 December 2022. Retrieved 29 December 2022.
- ↑ Self, Wesley H.; Wunderink, Richard G.; Williams, Derek J.; Zhu, Yuwei; Anderson, Evan J.; Balk, Robert A.; Fakhran, Sherene S.; Chappell, James D.; Casimir, Geoffrey; Courtney, D. Mark; Trabue, Christopher; Waterer, Grant W.; Bramley, Anna; Magill, Shelley; Jain, Seema; Edwards, Kathryn M.; Grijalva, Carlos G. (1 August 2016). "Staphylococcus aureus Community-acquired Pneumonia: Prevalence, Clinical Characteristics, and Outcomes". Clinical Infectious Diseases. 63 (3): 300–309. doi:10.1093/cid/ciw300. Archived from the original on 6 January 2023. Retrieved 6 January 2023.
- ↑ Licitra, Giancarlo. "Etymologia: Staphylococcus - Volume 19, Number 9—September 2013 - Emerging Infectious Diseases journal - CDC". doi:10.3201/eid1909.et1909. Archived from the original on 10 August 2022. Retrieved 31 December 2022.
- ↑ Lam, John C.; Stokes, William (January 2023). "The Golden Grapes of Wrath – Staphylococcus aureus Bacteremia: A Clinical Review". The American Journal of Medicine. 136 (1): 19–26. doi:10.1016/j.amjmed.2022.09.017.
External links
| Classification |
|
|---|
